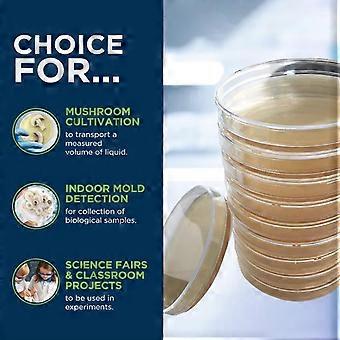
product image

Burgonya-dextróz agar Petri-csésze gombákhoz, otthoni tesztkészlet, 10 db
+ 3 949,00 Ft szállítási költség

Burgonya-dextróz agar Petri-csésze gombákhoz, otthoni tesztkészlet, 10 db
- Márka: Unbranded
Burgonya-dextróz agar Petri-csésze gombákhoz, otthoni tesztkészlet, 10 db
- Márka: Unbranded
Megtakarítás 2 300,00 Ft (23%)
RRP
14 napos visszaküldési szabályzat
Megtakarítás 2 300,00 Ft (23%)
RRP
14 napos visszaküldési szabályzat
A következő fizetési módokat fogadjuk el
Leírás
Burgonya-dextróz agar Petri-csésze gombákhoz, otthoni tesztkészlet, 10 db
- Márka: Unbranded
- Kategória: Petri csészék
- Fruugo azonosító: 351763893-766416975
- EAN: 4714159424216
Termékbiztonsági információk
Kérjük, olvassa el a termékre vonatkozó biztonsági információkat az alábbiakban
Az alábbi információkat a terméket értékesítő független, harmadik fél kiskereskedő biztosítja.
Kiszállítás és visszaküldés
Feladott 24 órán belül
-
STANDARD: 3 949,00 Ft - közötti szállítás Sze 24 december 2025–P 02 január 2026
Szállítás innen: Kína.
Minden tőlünk telhetőt megteszünk annak biztosítására, hogy rendelését hiánytalanul és előírásainknak megfelelően szállítás ki önnek. Viszont ha egy hiányos rendelést kap, vagy eltér a megrendelttől, vagy bármilyen más okból nem elégedett a rendeléssel, akkor visszaküldheti a rendelést vagy a rendelésben lévő bármely terméket, és visszatérítik a termék árának teljes összegét. Teljes visszaküldési irányelvek megtekintése.
Termékmegfelelőségi részletek
Kérjük, tekintse meg a termékre vonatkozó megfelelőségi információkat az alábbiakban.
Az alábbi információkat a terméket értékesítő független, harmadik fél kiskereskedő biztosítja.
Gyártó:
Az alábbiakban olvashatók a Fruugo platformján értékesített releváns termék gyártójának elérhetőségei.
- Shenzhen Haoyouqu Electronics Co., Ltd.
- Shenzhen Haoyouqu Electronics Co., Ltd.
- Tian'an Community
- Shatou Subdistrict
- Futian District
- shenzhen
- CN
- 518000
- woebgueh@outlook.com
- 15320490316
Felelős személy az EU-ban:
Az alábbiakban olvashatók az Európai Unióban kijelölt felelős személy elérhetőségei. A felelős személy az az Európai Unióban székhellyel rendelkező gazdasági társaság, amely az Európai Unióban eladott releváns termékekhez kapcsolódó megfelelőségi kötelezettségekért felel.
- 0utong GmbH
- 0utong GmbH
- Brehmstr, 56,40239 Duesseldorf
- Düsseldorf
- Germany
- 40239
- info@outong.de
- 4921131054698